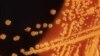

جهانی را تصور کنید که در آن بدن شما و فرزندان و عزیزانتان این قابلیت را داشته باشد که بتوانید آن را مطابق نیاز و نظر خود اصلاح کنید. مثلاً اگر در خانوادهای هستید که سابقۀ سرطان پستان در آن رواج دارد، بتوانید با یک تزریق ساده خود و همۀ نسلهای بعد از خود را از ابتلا به این بیماری در امان نگاه دارید.
یا بتوانید بخش زیستی اثرگذار در ضریب هوشی فرزندان و نسلهای بعدی را افزایش دهید، عوامل ژنتیکی بیماریهای قلبی و عروقی را از نقشۀ ژنتیک آنها حذف کنید، اگر فردی با نوع خاصی از نابینایی به دنیا آمد بار دیگر بینایی را به او بازگردانید و یا زمانی که با بیماری خاصی مواجه میشوید، بتوانید نسخۀ شخصیشدهای از داروها را برای درمان به دست بیاورید.
یا حتی بتوانید با حذف یا دستکاری ژنهایی که مسئولیت بروز سالخوردگی را دارند، مرگ را به تأخیر بیندازید یا اصلاً آن را حذف کنید.
این تصوری فانتزی نیست و دانشمندان میگویند ما اکنون در طلیعۀ چنین دنیایی زندگی میکنیم.
ویرایش ژنی
فکر ویرایش ژنی انسان و سایر جانوران نهتنها فکر تازهای نیست که قدمتش حتی به پیش از دورانی میرسد که با مفهوم ژنتیک آشنا شده بودیم. دنیای اطراف ما حاصل اصلاح و ویرایش ژنی است. گندمی که امروز وجود دارد, میوهها و حتی بسیاری از جانوران سابقۀ طولانی در تاریخ ندارند.
مثال معروف این داستان موجوداتی هستند که به نام «بهترین دوست انسان» میشناسیم. سگها در تاریخ وجود نداشتند بلکه از خانوادۀ گرگها بودند و با انتخاب انسان جدا شدند. ما در طول تاریخ با انتخاب تولهگرگهایی که بهدلایل مختلف بیشتر میپسندیدیم و وادار کردن آنها به تولیدمثل، گونههای مختلف سگها را به وجود آوردهایم. همین داستان دربارۀ انواع گیاهان و میوهها و جهان اطراف ما نیز مصداق دارد.
زمانی که دانشمندان با علم ژنتیک آشنا شدند و بهطور خاص به وجود و عملکرد ساختار دی.ان.ای پی بردند، منطق حاکم بر فرآیند این روش و مسئلۀ توارث را بهتر درک کردند.
مارپیچ دیانای
از آن زمان تاکنون راهی طولانی را طی کردهایم. حالا نقشۀ ژنتیک بسیاری از موجودات ازجمله انسان را داریم و بهسادگی میتوانیم، حتی در مقیاس تجاری و با هزینهای ارزان، اطلاعات دیانای افراد را ثبت کنیم.
چهار ترکیب شیمیایی که با حروف اختصاری A و C و G و T شناخته میشوند، اساس و بنیان رمزنگاری هستی زیستی ما هستند. این چهار مولکول بهصورت جفت به هم متصل میشوند و وقتی سه میلیارد و دویست میلیون جفت از این ترکیبات کنار هم قرار گرفت، رشتۀ دوگانۀ درهمپیچیدۀ دیانای شکل میگیرد؛ مولکولی عظیم که اگر از حالت درهمتنیده خارج شود، طول آن به دو متر میرسد و درون تکتک سلولهای من و شما قرار دارد.
هر بخشی از این نقشۀ حیاتی تعیینکنندۀ بخشی از ویژگیهای زیستی ما است. در همین مسیر پرپیچوتاب کدهایی قرار دارد که مشخص میکند رنگ موی شما چیست یا اینکه چشم شما قرار است در چه زمانی شروع به دوربین شدن کند، یا کدام سرطان در کمین شما است.
چسب، قیچی و دیانای
روش ویرایش ژنتیک بر این اساس است که با شناسایی بخشی از دیانای – توالی از جفت حروف که مسئول عارضهای ویژه است – بتوانیم با موفقیت و بدون اینکه آسیبی به سایر بخشهای این رشته بزنیم، آنها را قطع یا مطابق میل خود اصلاح کنیم.
روشهایی که تا پیش از انقلاب کریسپر وجود داشتند، خطای بالایی برای این اصلاحات در خود داشتند. به این معنا که اولاً با قطعیت نمیشد آنها را به سمت بخش هدف رشتۀ دیانای راهنمایی کرد و پس از رسیدن به آن امکان قطع دقیق بخش موردنظر با دقت بالا وجود نداشت و ممکن بود بخشهای دیگری از رشته قطع شود.
این روند در اوایل دهه ۲۰۱۰ دگرگون شد. گروهی از محققان که در حال بررسی و مطالعه روی سیستم دفاعی باکتریها بودند، متوجه شدند این موجودات از سیستم دفاعی در مقابل حملۀ ویروسها استفاده میکنند که میتوان بهسادگی آن را برای مقاصد دیگر به کار گرفت.
این ساختار دستگاهی به نام کریسپر بود که سرواژۀ عبارت طولانی تناوبهایِ کوتاهِ پالیندرومِ فاصلهدارِ منظمِ خوشهای است (Clustered Regularly Interspaced Short Palindromic Repeats). اما اجازه ندهید این اسم طولانی شما را به هراس بیندازد. داستان اصلی حداقل بهشکل کلی ساده است.
وقتی ویروسی وارد باکتری میشود و به آن حمله میکند، باکتری بخشهایی از دیانای ویروس را که مشخصۀ آن ویروس است جدا میکند و براساس تکرار آن توالی آرایهای میسازد که به نام کریسپر معروف است. حالا هر بار دیگر که آن ویروس به باکتری حمله کند، این ماشین مانند جاروبرقی رباتی روی نوار دیان ای ویروس حرکت میکند و بهمحض اینکه آن را پیدا کرد، آن را با کمک آنزیمی به نام کَس-۹ (Cas-9) قطع میکند.
این کار مانند استفاده از عملگرهای جستجو در یک فایل وُرد است. شما با وارد کردن توالی مشخصی از حروف میخواهید که کل متن شما جستجو شود و آن بخش را پیدا کند. حالا با بریدن یا همان کات میتوانید آن بخش را جدا کنید.
دانشمندان برای برنامهریزی این ماشین از یک RNA راهنما استفاده میکنند که به دستگاه میگوید کدام بخش را باید قطع کند. آنها همچنین میتوانند، با کمک یک رشته RNA اهداکننده، به سلول بگویند که بعد از اینکه این ماشین دیانای را در نقاط موردنظر بُرید، چطور دوباره خود را بازسازی کند.
به عبارت دیگر، این ترکیب حالا نهتنها میتواند دقیقاً در جایی که ما میخواهیم حروفی از دیانای مدنظر ما را ببُرد که میتواند دقیقاً حروفی را که ما میخواهیم جایگزین آن کند.
از همۀ اینها مهمتر اینکه این سیستم برخلاف بسیاری از روشهای پیشین که بهواسطۀ آنها تغییرات تنها بر ژنهای فرد مورد آزمایش اعمال میشد، میتواند روی ژنهای وراثتی عمل کند؛ به این معنا که شما با دستکاری ژن یک نفر میتوانید تمام نسلهای بعدی را نیز دستخوش تغییر کنید.
پیشگامان نگران و امیدوار
جنیفر دودنا و امانوئل شرپینته که در سال ۲۰۱۲ موفق به ابداع این روش شده بودند، در سال ۲۰۲۰ جایزۀ نوبل شیمی را دریافت کردند.
از ویژگیهای این روش تازه این است که غیر از دقیق بودن و بازه وسیع کاربردهایش، از نظر فنی بسیار ساده است و با هزینۀ کمی قابل انجام است. اگر در یوتیوب بگردید، انبوهی از آموزشهای انجام نمونههایی از دستکاری مبتنی بر کریسپر در خانه را خواهید یافت و همینطور شاهد رشد وسیع هکرهای زیستی (بایوهکرها) هستید که از این روش استفاده میکنند.
این فناوری همینطور بازار اقتصادی بزرگی دارد و انتظار میرود ارزش آن تا سال ۲۰۲۵ به حدود هفت میلیارد دلار برسد که نسبت به سال ۲۰۲۰ شاهد ۲۵ درصد رشد است.
با این حال، این فناوری قدرتمند بحث اخلاقی وسیعی را ایجاد کرده است که آیا داشتن توان چنین دستکاری عظیمی در بافتار نقشۀ زیستی انسان و جهان به این معنا است که باید آن را به کار هم ببریم؟
جنیفر دودنا معتقد است که ما بهطور خاص در مورد آزمایشهای انسانی باید صبوری به خرج دهیم و اجازه ندهیم یک آزمایش خطا کل رشد فناوری با همۀ امکاناتش را در خطر قرار دهد.
حجم توانایی این فناوری که یکی از انقلابهای مهم در قرن ۲۱ به شمار میرود، چه برای مقاصد خیر و چه برای مقاصد شر، چنان عظیم است که فکر کردن به آن نفس هر کسی را در سینه حبس میکند.